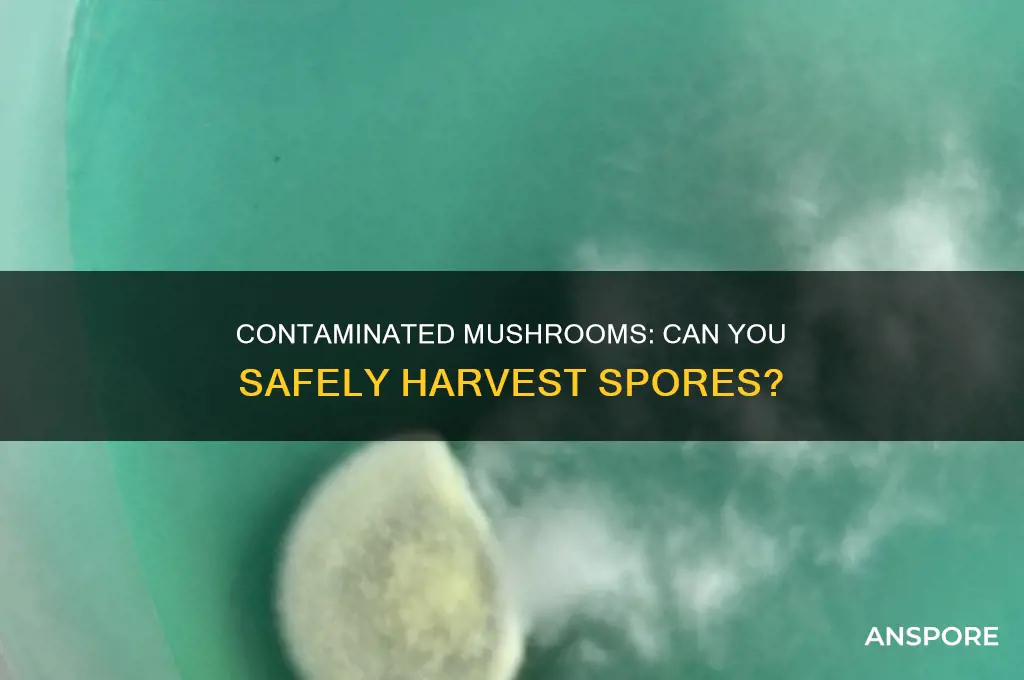
can you still get spores from contaminated mushrooms

The question of whether spores can still be obtained from contaminated mushrooms is a critical one, particularly for mycologists, cultivators, and enthusiasts. Contamination, often caused by bacteria, mold, or other fungi, can compromise the integrity of mushroom cultures, raising concerns about the viability and safety of their spores. While contaminated mushrooms may still produce spores, the risk of these spores carrying harmful microorganisms or being genetically compromised is significant. Therefore, it is essential to carefully assess the contamination level and type before attempting spore collection, as using spores from contaminated sources can lead to failed cultivations or the spread of unwanted pathogens. Proper sterilization techniques and isolation methods are crucial to ensure the purity and reliability of any spores harvested from such specimens.
| Characteristics | Values |
|---|---|
| Contamination Type | Bacterial, fungal, or chemical contaminants can affect mushrooms. |
| Spores Viability | Spores from contaminated mushrooms may still be viable, depending on the type and extent of contamination. |
| Bacterial Contamination | Spores can survive bacterial contamination if the bacteria do not directly affect the spore-producing structures (e.g., gills). |
| Fungal Contamination | Contamination by other fungi may compete with or inhibit spore production, but spores can still be present if the contamination is localized. |
| Chemical Contamination | Chemical contaminants (e.g., pesticides, heavy metals) may reduce spore viability or prevent spore release if they damage the mushroom's reproductive structures. |
| Spore Collection | Spores can be collected from contaminated mushrooms using sterile techniques, but contamination risk remains. |
| Spore Germination | Contaminated spores may germinate, but success depends on the contaminant's impact on spore health. |
| Safety Concerns | Spores from contaminated mushrooms may carry harmful contaminants, posing risks if used for cultivation or consumption. |
| Prevention | Proper cultivation practices (e.g., sterile environment, clean substrates) reduce contamination risk and preserve spore quality. |
| Testing | Spores can be tested for contamination using microscopy, culturing, or molecular methods to ensure viability and safety. |
Explore related products
What You'll Learn
- Identifying Contamination Signs: Look for mold, discoloration, or unusual textures indicating contamination in mushroom samples
- Safe Spore Extraction Methods: Use sterile tools and techniques to minimize contamination risk during spore collection
- Contamination Risks: Understand how bacteria, fungi, or chemicals can render spores unusable or harmful
- Testing for Viability: Check spore viability post-extraction to ensure they can germinate despite contamination
- Preventive Measures: Maintain clean environments and use proper storage to avoid contamination in mushroom cultures

Identifying Contamination Signs: Look for mold, discoloration, or unusual textures indicating contamination in mushroom samples
Contaminated mushrooms often reveal their compromised state through visible and tactile cues that even novice foragers can learn to identify. Mold is perhaps the most overt sign, appearing as fuzzy patches in colors ranging from white and green to black. These growths indicate fungal colonization, which not only spoils the mushroom but also poses health risks if ingested. Discoloration is another red flag; while some mushrooms naturally darken with age, irregular brown, yellow, or gray spots suggest bacterial or fungal contamination. Unusual textures, such as sliminess or a mushy consistency, further signal decay, often caused by excess moisture or microbial activity. Recognizing these signs is crucial, as contaminated mushrooms may still produce spores, but their viability and safety are questionable.
Analyzing these contamination signs requires a systematic approach. Start by examining the mushroom’s surface under good lighting, noting any deviations from its typical appearance. For instance, a chanterelle should have a uniform golden hue, so any dark spots warrant scrutiny. Texture assessment follows; healthy mushrooms feel firm but pliable, while contaminated ones may feel overly soft or sticky. Smell is another diagnostic tool—a sour or ammonia-like odor often accompanies mold or bacterial growth. If contamination is suspected, avoid handling the mushroom without gloves, as spores and pathogens can transfer easily. While spores from contaminated mushrooms may still be present, their quality is likely compromised, making them unsuitable for cultivation or study.
Persuasively, the risks of using spores from contaminated mushrooms far outweigh the benefits. Even if spores appear intact, they may carry contaminants that hinder germination or introduce pathogens into new cultures. For example, *Trichoderma* mold, a common contaminant, can outcompete mushroom mycelium, leading to crop failure. Similarly, bacterial contamination can produce toxins that affect both the mushroom and the substrate. For hobbyists and professionals alike, investing time in identifying and discarding contaminated samples is far more cost-effective than dealing with failed grows or health issues. Prioritizing clean, uncontaminated specimens ensures the longevity and success of mushroom cultivation projects.
Comparatively, the signs of contamination in mushrooms share similarities with those in other organic materials but require unique considerations. For instance, mold on bread is easily identifiable but typically harmless in small amounts, whereas mold on mushrooms often indicates deeper issues due to their porous structure. Discoloration in fruits might result from bruising, but in mushrooms, it often signifies microbial invasion. Texture changes in vegetables like lettuce are usually due to dehydration, whereas in mushrooms, they point to decay. These distinctions highlight the importance of mushroom-specific knowledge. While spores from contaminated mushrooms might technically be collectible, their utility pales in comparison to those from pristine samples, making careful inspection indispensable.
Descriptively, a contaminated mushroom is a study in deterioration, its once-vibrant form now marred by the encroachment of foreign organisms. Mold colonies spread like cobwebs across its cap and stem, their colors clashing with the mushroom’s natural palette. Discoloration creeps in, transforming smooth surfaces into patchworks of decay. The texture, once inviting, becomes repellent—slimy to the touch, as if the mushroom is melting from within. These changes are not merely aesthetic; they are warnings of a compromised structure, both physically and biologically. While spores may still cling to the gills or pores, their surroundings tell a story of decline, raising doubts about their ability to thrive in new environments. For the discerning observer, these signs are a call to discard rather than salvage.
Profitable Mushroom Farming: Can You Earn Big Growing Gourmet Fungi?
You may want to see also

Safe Spore Extraction Methods: Use sterile tools and techniques to minimize contamination risk during spore collection
Contaminated mushrooms often host competing molds, bacteria, or other fungi that can outcompete the desired spores during extraction. However, with meticulous sterile techniques, it is still possible to isolate viable spores. The key lies in minimizing contamination risk through every step of the process, from tool preparation to spore collection.
Sterilization is paramount. Begin by sterilizing all equipment, including scalpel blades, glass slides, and storage vials, using a pressure cooker (autoclave) at 15 psi for 30 minutes or an open flame for metal tools. For surfaces, a 70% isopropyl alcohol solution or 10% bleach wipe-down followed by thorough drying under a sterile laminar flow hood is essential. Even the slightest oversight can introduce contaminants that compromise the entire extraction.
Technique matters as much as tools. Work in a clean, draft-free environment, ideally with a gloved-box or laminar flow hood to minimize airborne particles. When handling the mushroom, use flame-sterilized forceps to excise a small, uncontaminated portion of the cap, avoiding areas with visible mold or decay. Gently place the tissue on a sterile glass slide, cover with a second slide, and apply slight pressure to release spores without crushing the tissue. This method ensures minimal disturbance to the mushroom’s structure, reducing the risk of contaminant transfer.
Storage and verification are critical final steps. Collect the spores using a sterile inoculation loop or pipette, transferring them to a sterile agar plate or spore syringe pre-filled with distilled water. Store the sample in a sealed vial at 4°C to preserve viability. To confirm purity, streak a portion of the spore suspension onto nutrient agar and incubate at 25°C for 7–10 days. Inspect for any growth other than the target fungus; if contaminants appear, discard the sample and repeat the process with stricter sterilization measures.
By adhering to these sterile tools and techniques, even contaminated mushrooms can yield viable spores for cultivation or study. The precision required underscores the importance of patience and attention to detail in mycological work.
Can Mushrooms or Fungi Thrive in the Human Digestive System?
You may want to see also

Contamination Risks: Understand how bacteria, fungi, or chemicals can render spores unusable or harmful
Spores from contaminated mushrooms are not inherently unusable, but their viability and safety hinge on the type and extent of contamination. Bacteria, fungi, or chemicals can compromise spore integrity, rendering them ineffective for cultivation or harmful for use. For instance, bacterial contamination often manifests as slimy textures or off-odors, signaling the presence of microbes that outcompete mushroom mycelium. Such spores, even if present, may fail to germinate due to resource depletion or physical damage from bacterial enzymes. Similarly, fungal contaminants like Trichoderma can overrun mushroom cultures, producing spores that are either mixed with the contaminant or inhibited from forming altogether. Chemical contaminants, such as pesticides or heavy metals, can mutate or kill spores outright, making them unsuitable for any purpose.
To mitigate these risks, cultivators must adopt rigorous sterilization practices. Autoclaving substrates at 121°C (250°F) for 30–60 minutes effectively eliminates most microbial contaminants, while using filtered air and sterile tools minimizes reintroduction. For chemical contaminants, sourcing organic materials and testing soil or water for toxins is essential. If contamination occurs, salvaging spores is possible but risky. A contaminated culture should be isolated, and spores harvested only after thorough examination under a microscope to ensure purity. However, even visually clean spores may carry latent contaminants, making them unreliable for sensitive applications like medicinal mushroom cultivation.
The impact of contamination extends beyond spore viability to human health. Consuming spores from contaminated mushrooms can introduce pathogens or toxins into the body, particularly dangerous for immunocompromised individuals or those using spores for medicinal purposes. For example, Aspergillus contamination can produce aflatoxins, potent carcinogens even in minute quantities. Similarly, bacterial contaminants like Salmonella or E. coli pose severe risks if ingested. Therefore, any suspicion of contamination should disqualify spores from consumption or medical use, regardless of their apparent condition.
Comparatively, while some contaminants only affect spore usability, others render them outright dangerous. Bacterial and fungal competitors typically reduce yield or viability but are less likely to produce toxins. Chemical contaminants, however, pose a dual threat by damaging spores and introducing harmful substances. For instance, heavy metal contamination not only inhibits spore germination but also accumulates in mushroom tissues, posing long-term health risks if consumed. This distinction underscores the importance of identifying the contamination type before deciding whether to salvage spores or discard the entire culture.
In practice, prevention is far more effective than remediation. Cultivators should prioritize cleanroom techniques, such as HEPA filtration and regular disinfection of equipment. For home growers, simple measures like using pressure cookers for sterilization and purchasing spores from reputable suppliers can significantly reduce contamination risks. If contamination does occur, documenting its type and extent can guide future prevention strategies. While it is technically possible to extract spores from contaminated mushrooms, the risks often outweigh the benefits, making contamination avoidance the cornerstone of successful spore cultivation.
Mushrooms and Seaweed: Cooking Together in One Pot?
You may want to see also
Explore related products

Testing for Viability: Check spore viability post-extraction to ensure they can germinate despite contamination
Contaminated mushrooms often raise concerns about the viability of their spores, but extraction doesn’t automatically render them useless. Testing spore viability post-extraction is crucial to determine if they can still germinate, ensuring your efforts aren’t wasted. This process involves assessing whether the spores remain alive and capable of growth despite exposure to contaminants like bacteria, mold, or foreign particles. Without this step, you risk investing time and resources in spores that may never develop into mycelium.
To test spore viability, start by preparing a nutrient-rich agar medium, such as potato dextrose agar (PDA), which supports fungal growth. Sterilize the agar and allow it to cool to around 50°C before pouring it into Petri dishes. Once solidified, inoculate the agar with a small sample of the extracted spores using a sterile technique to avoid introducing new contaminants. Incubate the dishes at 22–26°C for 7–14 days, monitoring for signs of germination. Healthy spores will produce visible mycelial growth, while non-viable spores will show no activity.
A key caution is to avoid over-relying on visual inspection alone. Contamination can sometimes mimic early mycelial growth, so confirm results using a microscope. Examine the cultures for distinct fungal hyphae, which appear as thread-like structures, versus bacterial colonies or mold, which have different morphologies. If contamination is present, consider using antibiotics like streptomycin (50–100 mg/L) in the agar to suppress bacterial growth without harming the spores. This step ensures accurate assessment of spore viability.
Comparatively, viable spores from contaminated mushrooms often show slower germination rates than those from pristine sources. However, with proper handling and testing, they can still produce robust mycelium. For example, a study on * Psilocybe cubensis* spores extracted from contaminated substrates found that 70% germinated successfully after antibiotic treatment and viability testing. This highlights the importance of not discarding contaminated material prematurely.
In conclusion, testing spore viability post-extraction is a practical and necessary step to salvage potentially useful spores from contaminated mushrooms. By following precise protocols, using appropriate media, and employing confirmatory techniques, you can ensure that your spores are capable of germination. This approach not only maximizes resource efficiency but also opens opportunities to work with materials that might otherwise be overlooked.
Can Magic Mushrooms Absorb Through Skin? Exploring Transdermal Psilocybin Potential
You may want to see also

Preventive Measures: Maintain clean environments and use proper storage to avoid contamination in mushroom cultures
Contamination in mushroom cultures can render spores unusable, but preventive measures significantly reduce this risk. A clean environment is the cornerstone of successful mushroom cultivation. Spores are highly susceptible to airborne contaminants like bacteria, mold, and competing fungi. Even a single spore of a contaminant can outcompete your desired mushroom species, leading to a failed harvest.
Regularly disinfecting surfaces with a 10% bleach solution or a specialized fungicide designed for mushroom cultivation is crucial. HEPA filters can be employed to minimize airborne particles, and positive air pressure systems can prevent contaminants from entering grow rooms.
Proper storage of mushroom cultures and spores is equally vital. Spores should be stored in airtight containers, preferably glass vials with rubber stoppers, at a cool temperature between 2-8°C (36-46°F). This slows down metabolic activity and prevents the growth of contaminants. For long-term storage, consider vacuum sealing spores or using desiccants to remove moisture, a key factor in spore viability and contamination risk. Label all containers clearly with the mushroom species, date of collection, and any relevant notes.
Proper storage not only preserves spore viability but also prevents accidental cross-contamination between different mushroom strains.
While it's possible to isolate spores from contaminated mushrooms, it's a risky and time-consuming process. Contaminants can easily be transferred to the new culture, leading to further problems. Preventive measures are far more effective and efficient. By maintaining a clean environment and employing proper storage techniques, you drastically increase the chances of successful mushroom cultivation and ensure the viability of your precious spores. Remember, an ounce of prevention is worth a pound of cure, especially in the delicate world of mushroom cultivation.
Mushrooms as Divine Entities: Exploring the Sacred Fungal Connection
You may want to see also
Frequently asked questions
Yes, you can still collect spores from contaminated mushrooms, but the contamination may affect the viability or purity of the spores.
Contaminated spores may show signs of mold, discoloration, or unusual growth patterns when cultured, indicating the presence of unwanted organisms.
Using spores from contaminated mushrooms carries a risk of introducing contaminants into your grow environment, which can hinder or ruin the cultivation process.
To minimize contamination, work in a sterile environment, use sterile tools, and ensure the mushroom is as clean as possible before collecting spores.











































